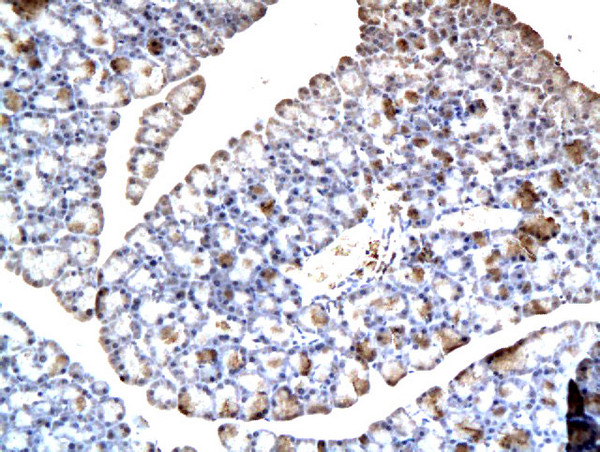
BSEP/ABCB11 Antibody in Immunohistochemistry (Paraffin) (IHC (P))

Search
Bioss
BSEP/ABCB11 Polyclonal Antibody
{{$productOrderCtrl.translations['antibody.pdp.commerceCard.promotion.promotions']}}
{{$productOrderCtrl.translations['antibody.pdp.commerceCard.promotion.viewpromo']}}
{{$productOrderCtrl.translations['antibody.pdp.commerceCard.promotion.promocode']}}: {{promo.promoCode}} {{promo.promoTitle}} {{promo.promoDescription}}. {{$productOrderCtrl.translations['antibody.pdp.commerceCard.promotion.learnmore']}}
产品信息
BS-1954R
种属反应
宿主/亚型
分类
类型
抗原
偶联物
形式
浓度
规格
纯化类型
保存液
内含物
保存条件
运输条件
靶标信息
ABCB11 is involved in the ATP-dependent secretion of bile salts into the canaliculus of hepatocytes. It is expressed predominatly, if not exclusively, in the liver, where it is further localized to the canilicular microvilli and to subcanilicular vesicles fo the hepatocytes. Structurally, ABCB11 is a multifunctional polypeptide with two homologus halves, each containing a hydrophobic membrane-anchoring domain and an ATP binding cassette (ABC) domain. Defects in ABCB11 are the cause of progressive familial intrahepatic cholestasis 2 (PFIC2). PFIC2 is an inherited liver disease of childhood which is characterized by cholestasis and normal serum gamma-glutamyltransferase activity. Defects in ABCB11 are also found in cases of chronic intrahepatic cholestasis without obvious familial history of chronic liver disease.
仅用于科研。不用于诊断过程。未经明确授权不得转售。
篇参考文献 (0)
生物信息学
蛋白别名: ABC member 16, MDR/TAP subfamily; ABC transporter; ATP-binding cassette sub-family B member 11; ATP-binding cassette, sub-family B (MDR/TAP), member 11; ATP-binding cassette, sub-family B, member 11; Bile salt export pump; progressive familial intrahepatic cholestasis 2; Sister of P-glycoprotein; sister p-glycoprotein; unnamed protein product
基因别名: ABC16; ABCB11; BRIC2; BSEP; Lith1; PFIC-2; PFIC2; PGY4; SPGP
UniProt ID: (Human) O95342, (Rat) O70127, (Mouse) Q9QY30
Entrez Gene ID: (Human) 8647, (Rat) 83569, (Mouse) 27413